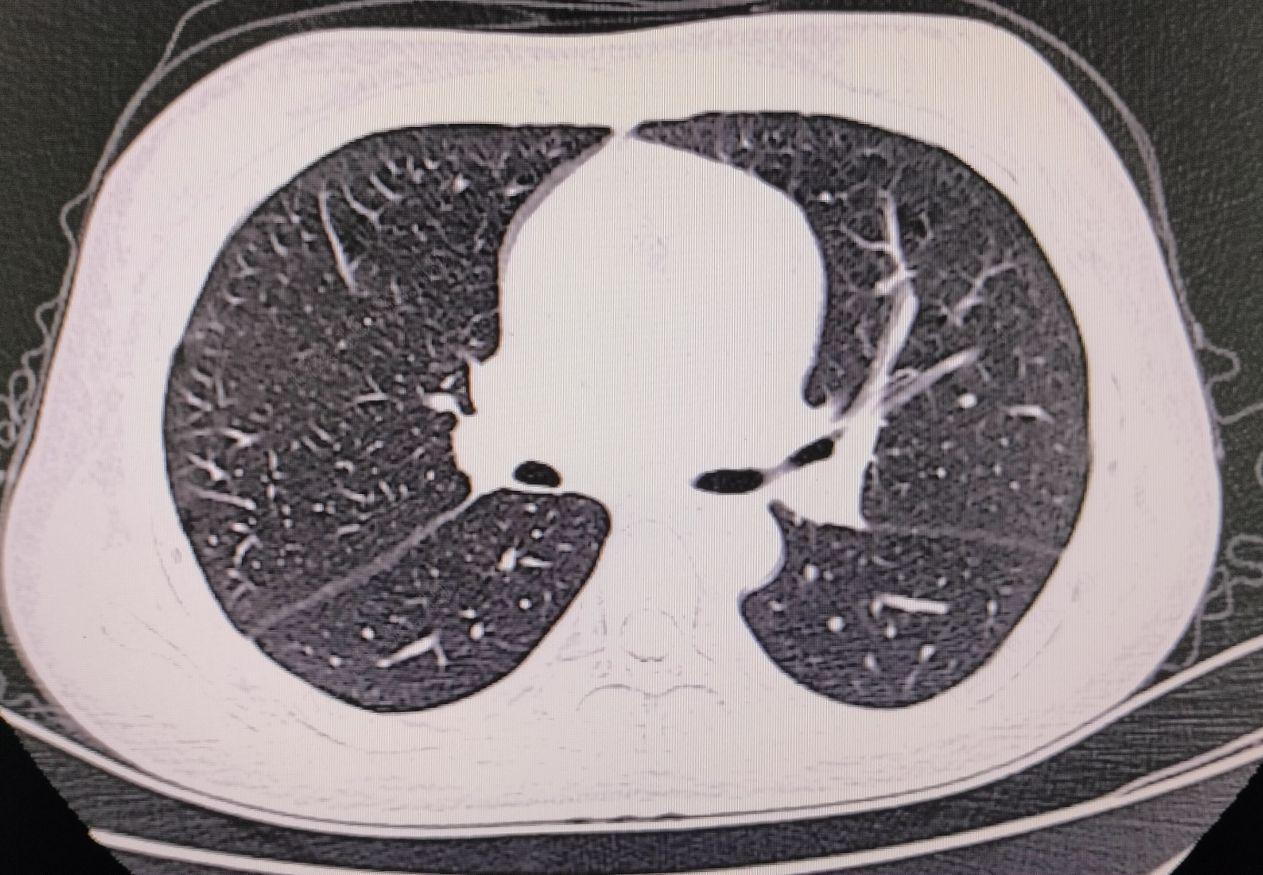

【基本信息】女、14、学生
【发病原因】双下肢皮疹半月余,蛋白尿1周
【临床诊断】1.狼疮性肾炎;2.系统性红斑狼疮
【治疗方案】贝利尤单抗550mg静脉滴注免疫调节、甲泼尼龙琥珀酸钠50mg静脉滴注抗炎、注射用泮拉唑抑酸护胃、补充钙剂、对症支持治疗
【治疗结果】好转出院
【病案重点】系统性红斑狼疮、狼疮性肾炎
双下肢皮疹半月余,蛋白尿1周。
患者缘于半月前无明显诱因出现双下肢出现密集分布的紫红色皮疹,略高出皮面,双侧对称分布,压之不退色,无关节疼痛,无腹痛腹胀,无畏寒发热,在家未用药治疗,皮疹增多。1周前患者出现双下肢水肿,伴解泡沫尿,我院门诊查尿常规提示蛋白2+,症状反复,后双下肢水肿较前加重,再次就诊我院,门诊查生化提示清蛋白31.4g/L,尿微量白蛋白3535.1mg/L,为进一步治疗,门诊拟过敏性紫癜性肾炎收入我科,自发病来,患者精神睡眠正常,大小便正常,体重无明显下降。
一般健康状况:良好;疾病史:既往无高血压、糖尿病病史;传染病史:无传染病史,无传染病接触史;手术外伤史:手术史:无,外伤史:无;输血史:无;过敏史:药物过敏史:无;食物过敏史:无;预防接种史:新冠疫苗已接种(3)剂,其余不详。
生于原籍,无外地久居史,生活规律,无吸烟史;否认饮酒史,无毒物、粉尘及放射性物质接触史,否认冶游史,无重大精神创伤史。
T: 36.6℃,P: 76次/分,R: 20次/分,BP: 164/114mmHg。
一般情况:神志清醒,精神正常,发育正常,营养良好,自主体位,查体合作。皮肤黏膜:无黄染,无出血点。浅表淋巴结:未触及肿大。头部及其器官:头颅形状:正常,眼睑正常、无充血、无苍白,双侧瞳孔等圆、等大,对光反射存在。耳鼻正常,口唇无发绀,扁桃体无肿大、无化脓。颈部:颈软,气管居中,甲状腺无肿大,无颈静脉怒张。胸部:胸廓对称,双侧呼吸运动对称,双肺未及干湿啰音。心前区无隆起,心界正常,心率76次/分,律齐,各瓣膜听诊区未闻及病理性杂音。腹部:全腹软,全腹无压痛、无反跳痛,肝肋缘下,剑突下,质软,边缘整齐,无触痛;脾未触及。移动性浊音(无)。肠鸣音正常。直肠肛门:未查。外生殖器:外观正常。脊柱:脊柱生理弯曲存在,四肢:四肢关节无畸形,四肢活动自如,双下肢出现密集分布的紫红色皮疹,略高出皮面,双侧对称分布,压之不退色,双下肢轻度水肿。神经系统:腹壁反射正常,膝腱反射正常,巴氏征阴性,脑膜刺激征阴性。
专科情况:双下肢出现密集分布的紫红色皮疹,略高出皮面,双侧对称分布,压之不退色,双下肢轻度水肿。
血常规:红细胞3.45*10^12/L,血红蛋白93g/L,红细胞压积27.3%,血小板129*10^9/L。尿常规:红细胞776个/uL,蛋白2+。凝血功能正常。生化:总蛋白82.3g/L,清蛋白31,尿微量蛋白3535.1mg/L。铁蛋白测定196ng/ml,尿酸459.9umol/L,钙2.05mmol/l,C反应蛋白11.6mg/L,抗核抗体提物示:抗Sm抗体阳性,Scl-70弱阳性,重组Ro-52阳性,SS-B阳性,双链DNA阳性,核小体阳性,组蛋白阳性,干燥综合征相关抗原A/Ro60阳性,抗核抗体核颗粒型阳性(1:320)。大便常规、肾功能、心肌酶谱、血糖、血脂、肿瘤标功三项、乙肝五项、输血前三项未见异常,心电图示:正常范围心电图。胸部CT示:1、两肺少许小结节,拟增殖灶,2、心包、双侧胸腔少量积液。

过敏性紫癜性肾炎?
患者因双下肢皮疹半月余,蛋白尿1周入院,血小板、凝血功能正常,查体:双下肢出集分布的紫红色皮疹,略高出皮面,双侧对称分布,压之不退色,双下肢轻度水肿,辅助检查:尿常规:蛋白2+。生化:清蛋白31.4g/L,尿微量白蛋白3535.1mg/L。
1、急性肾衰:发病呈急性过程,病情进展较快,可有典型的无尿、少尿、多尿期变化,双肾彩超示双肾体积无明显变化,双肾彩超有助于鉴别。
2、急性肾炎:该病呈急性起病,起病前1至2周前多有上呼吸道感染病史,临床上有水肿,血压高,尿检异常,多无显著贫血,无双肾萎缩等有助于鉴别。
入院后予完善相关检查,贝利尤单抗550mg静脉滴注免疫调节、甲泼尼龙琥珀酸钠50mg静脉滴注抗炎、注射用泮拉唑抑酸护胃、补充钙剂、对症支持治疗,治疗5天,患者皮疹消退,复查蛋白尿减少,好转出院,出院后予酸泼尼松片抗炎,泮托拉唑肠溶片护胃,阿法骨化醇+碳酸钙D3片补钙、氯沙坦钾片降血压、护肾治疗,嘱定期门诊随诊。
1.狼疮性肾炎2.系统性红斑狼疮
该病例为少女,双下肢皮疹、蛋白尿入院,化验抗Sm抗体阳性,Scl-70弱阳性,SS-B阳性,双链DNA阳性,诊断系统性红斑狼疮、狼疮性肾炎明确。狼疮性肾炎(LN)分析总结发病机制:系统性红斑狼疮(SLE)的核心机制是自身免疫异常,产生大量自身抗体(如抗dsDNA抗体),形成免疫复合物沉积于肾脏,激活补体,引发炎症反应,导致肾小球、肾小管及间质的损伤。
遗传、环境和激素因素共同参与。临床表现:肾脏表现以蛋白尿(最常见)或血尿为核心,可进展为肾病综合征(大量蛋白尿、低蛋白血症、水肿)及高血压。急性期可出现急性肾损伤,慢性化则导致肾功能不全。常伴随SLE的全身症状,如面部蝶形红斑、关节痛、发热等。
诊断要点:
1. 确诊SLE:符合SLE分类标准。
2. 证实肾脏受累:持续蛋白尿>0.5g/天或管理尿(尤其红细胞管理)。
3. 金标准——肾活检:进行病理分型(国际肾脏病学会/肾脏病理学会ISN/RPS 2003分型,I-VI型),明确病变活动性和慢性化程度,指导治疗和判断预后。
治疗要点:治疗基于病理分型和疾病活动度,遵循诱导缓解、维持巩固的原则。
1. 基础治疗:严格控制血压(ACEI/ARB类药物兼具降压和降蛋白尿作用)、使用羟氯喹。
2. 诱导治疗:活动性LN(III、IV、V型等)常用激素联合免疫抑制剂(如环磷酰胺、霉酚酸酯、他克莫司等)。
3. 维持治疗:霉酚酸酯或硫唑嘌呤联合小剂量激素,长期维持以防复发。
4. 新型疗法:对难治性病例,可考虑贝利尤单抗、利妥昔单抗等生物制剂。治疗需全程监测疗效、副作用并预防感染。
总结:狼疮性肾炎是SLE最常见且严重的并发症,其本质是免疫复合物介导的肾小球肾炎。临床表现多样,诊断依赖临床指标和至关重要的肾活检病理。治疗强调个体化、分型施治,目标是尽快诱导缓解、保护肾功能、减少复发,同时兼顾药物安全性,改善患者长期预后。
本站所注明来源为"爱爱医"的文章,版权归作者与本站共同所有,非经授权不得转载。
本站所有转载文章系出于传递更多信息之目的,且明确注明来 源和作者,如果您认为我们的转载侵犯了您的